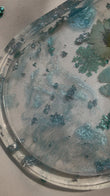

Frosted Trinket
Regular price
Rs.2,699.00
Sale price
Rs.2,699.00
Regular price
Bring a breath of calm to your space with the Frosted Trinket Tray. This handcrafted beauty features real pressed blue-toned flowers and foil flakes, all preserved in crystal-clear resin. Its soft, icy palette and botanical details make it a soothing accent for any vanity, desk, or shelf.
Whether you use it to hold rings, keys, tasbeeh, or sweet treats or little cups this tray adds both function and a serene, elegant touch to your everyday routine.
Why You’ll Love It:
-
Made with real pressed florals and shimmering foil
-
Hand-poured resin ensures each piece is one-of-a-kind
-
Light and versatile — perfect for gifting or styling your space
-
A calming color palette that matches minimal and dreamy aesthetics